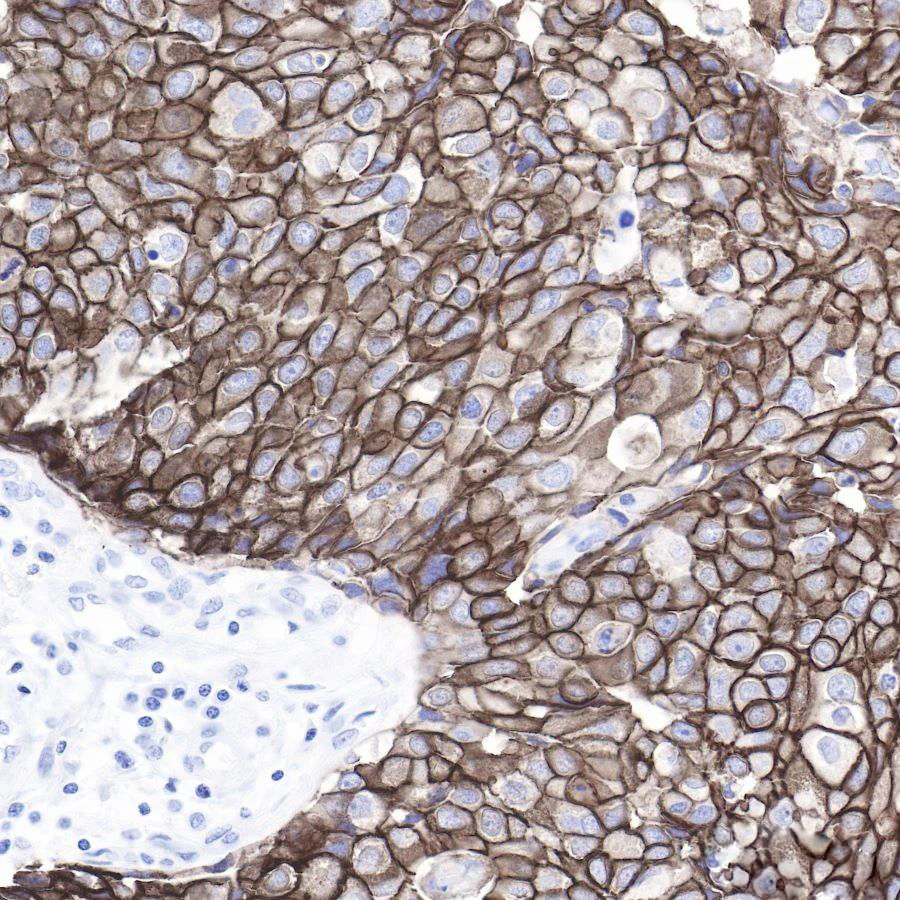
技术资料图片2
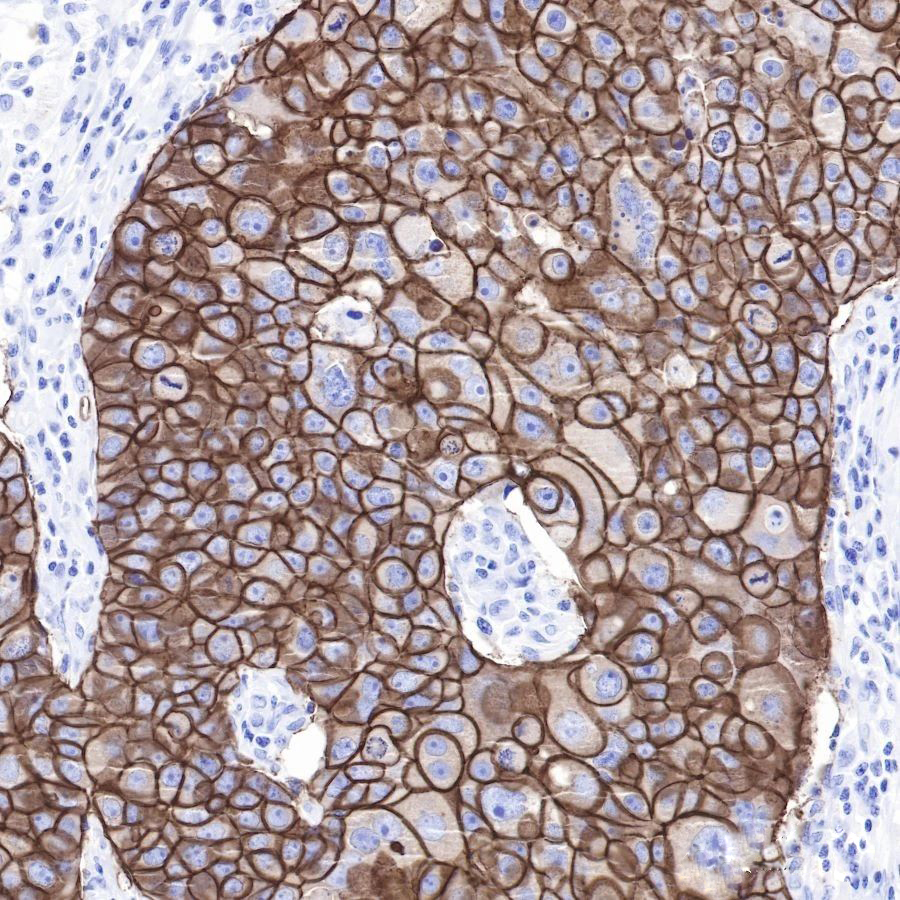
技术资料图片3

2 年
手机商铺
技术资料/正文
95 人阅读发布时间:2025-06-09 09:43
乳腺癌作为一种常见的恶性肿瘤,严重威胁着女性健康。然而,随着医学技术的不断发展,我们有了更为精准和有效的检测方法,为及早发现和治疗乳腺癌提供了强有力的支持。
在这篇文章中,我们将深入了解乳腺癌的IHC检测技术,并为您介绍斯达特生物推出的乳腺癌相关抗体,为您的健康保驾护航。

IHC检测技术:乳腺癌识别的利器
免疫组织化学(IHC)技术是一种通过标记特异性抗体来检测抗原的细胞化学方法。在乳腺癌检测中,IHC技术被广泛应用于HER2、ER、PR等乳腺癌相关抗原的检测。其中,HER2蛋白过表达的检测对于指导靶向治疗具有重要意义。斯达特的乳腺癌相关抗体,正是基于IHC技术而研发,为精准诊断和治疗乳腺癌提供了可靠的工具。
斯达特乳腺癌相关抗体
1、ErbB2
HER2 (ErbB2) 是人类表皮生长因子受体(HER/EGFR/ERBB)家族的一个成员。但与ERBB家族的其他成员相反,HER2并不直接结合配体。例如在癌症中,HER2的激活来自于与另一个ERBB成员的异源二聚体或当HER2浓度高时的同源二聚体。HER2基因的扩增或过度表达,从而促进肿瘤的生长和进展。HER2阳性乳腺癌患者通常具有更高的肿瘤增殖活性、更强的侵袭能力和更短的生存期。近年来,该蛋白已成为约30%的乳腺癌患者的重要生物标志物和治疗靶点。

2、LIV-1/SLC39A6
锌转运体LIV-1(SLC39A6)受雌激素调节。SLC39A6是ZIP运输体家族的一员,它通过调节锌从细胞外到细胞内的流入来控制锌的平衡。SLC39A6的锌转运功能在细胞代谢中起着重要作用。各种细胞过程都需要锌,包括免疫活动、蛋白质合成、核酸代谢、细胞增殖、组织修复和细胞分裂,低锌水平会导致代谢紊乱,抑制细胞生长。SLC39A6的过量表达与几种癌症的进展有关,包括乳腺癌、前列腺癌、胰腺癌、宫颈癌和肝癌,SLC39A6的过量表达促进上皮-间质转化(EMT)。

3、Mammaglobin A
Mammaglobin-A是一种新型的乳腺癌相关抗原,最初是用一种差异性筛选方法确定的。现已经证明MGBA有几个特性,使其成为免疫治疗的一个潜在靶点。对20多个不同人体组织的基因表达分析表明,MGBA几乎只在正常乳腺上皮和乳腺癌中表达。MGBA在高达80%的原发性和转移性乳腺癌中过度表达。

持续创新,助力乳腺癌防治
斯达特生物将继续致力于研发更多高质量的乳腺癌相关抗体,为IHC检测技术的进步提供有力支持。通过不断提高检测的特异性和灵敏度,我们希望帮助医生更好地诊断和治疗乳腺癌,让更多的患者重获健康和希望。
StarMab®相关产品
点击下方的产品货号,直达官网详情页供您了解。

杭州斯达特 (www.starter-bio.com)志在为全球生命科学行业提供优质的抗体、蛋白、试剂盒等产品及研发服务。依托多个开发平台:重组兔单抗、重组鼠单抗、快速鼠单抗、重组蛋白开发平台(E.coli,CHO,HEK293,InsectCells),已正式通过欧盟98/79/EC认证、ISO9001认证、ISO13485。